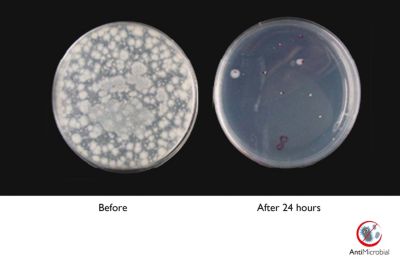
Antimicrobial housing actively inhibits bacterial growth

Discontinued
BrillianceLCD monitor with Clinical D-image
C272P4QPKEW/00
with Brilliant Images
Clinical Review Display
Clinical review display
27" (68.6 cm)
2560 x 1440 (3.6 MP)

Clinical D-image pre-set for DICOM part 14 Greyscale images
Monitors must show medical images consistently with high quality to achieve reliable interpretations. The rendering of medical Greyscale images on standard monitors is mostly inconsistent at best, making them unsuitable for use in a clinical environment. Philips clinical review displays with clinical D-image pre-set are factory-calibrated to give DICOM part 14 compatible Greyscale standard display performance. By using high-quality LCD panels with LED technology, Philips offers you consistent and reliable performance at an affordable price. Further info on http://medical.nema.org/
SmartImage Clinic for common display settings
SmartImage is an exclusive, leading-edge Philips technology that analyses the content displayed on your screen, and based on different applications/images displayed on a monitor, SmartImage optimises display content by dynamically adjusting brightness, contrast, colour and sharpness in real time.
Antimicrobial housing actively inhibits bacterial growth
Germs have become a growing problem in hospitals and clinical environments worldwide as they can cause life-threatening infections. Philips clinical review displays take care of this challenge by using a JIS Z2801-compliant antimicrobial additive in its housing material making it an integral part of the display housing. Your wellbeing, along with your patients, is now assured by this protective shield that impedes the growth of the most common microorganisms, such as "Staphylococcus aureus (Gastroenteritis)", "Escherichia coli (E Coli)" and "Klebsiella (Pneumonia)", for example.
Technical specifications
Sign up to the Philips newsletter for exclusive offers
- Member-exclusive offers.
- Early access to sales.
- News on product launches and tips for healthy lifestyles.
- Member-exclusive offers.
- Early access to sales.
- News on product launches and tips for healthy lifestyles.
Please note: Any use as a primary diagnostic tool is the sole responsibility of the hospital or clinic operator only.
DICOM is the registered trademark of the NEMA for its standards publications relating to digital communications of medical information.



